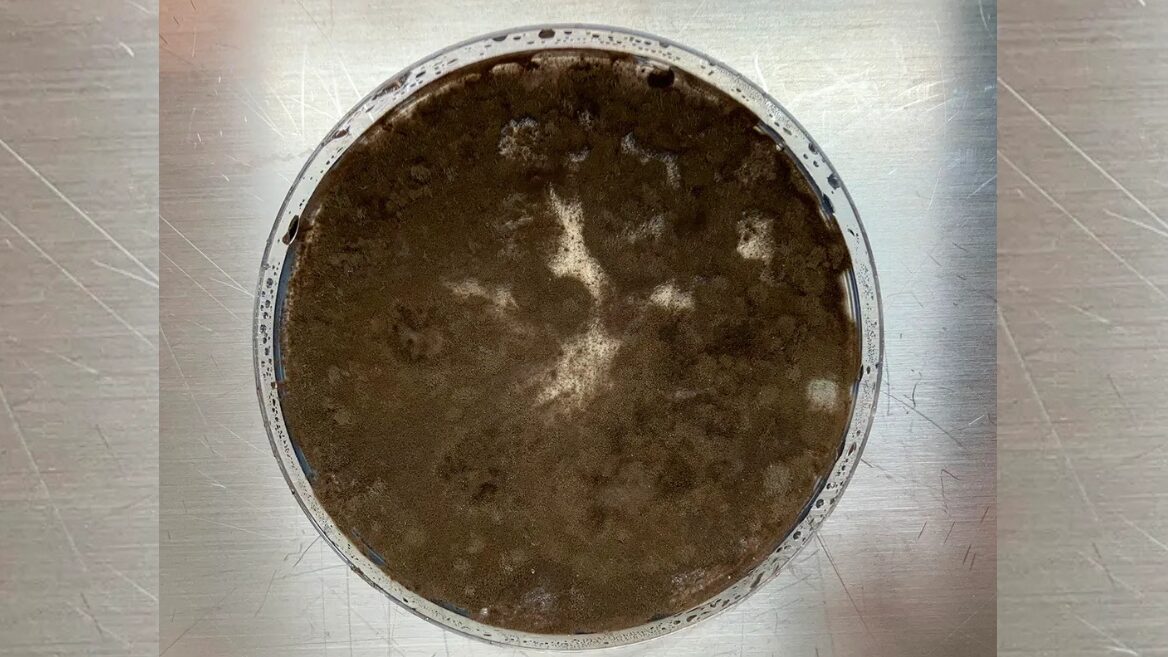

Гриби, які живляться радіацією
У 1997 році українська вчена Неллі Жданова виявила чорну цвіль, що колонізувала високорадіоактивні руїни Чорнобильської атомної електростанції. Вона зростала на стінах, стелях і навіть всередині будівлі реактора, пише Interesting Engineering.
Дослідження показало, що замість того, аби уникати токсичного середовища, гриби унікальним чином притягувалися до іонізуючого випромінювання, яке зазвичай руйнує ДНК та клітини. Виявилося, що випромінювання стало поживною речовиною для цих грибів.
Секрет, здавалося, полягав у меланіні. Той самий пігмент, що надає нам різних відтінків шкіри та захищає від УФ-променів, щільно упакований у клітинні стінки цих чорнобильських грибів. Початкові теорії припускали, що меланін захищає чорну плісняву.
Проте, дослідження, проведене у 2007 році іншими вченими, виявило ключовий факт: меланізовані гриби демонстрували зростання на 10% швидше під час опромінення радіоактивним Цезієм. Це вказувало на те, що вони активно використовували радіацію як джерело метаболічної енергії. Цей процес отримав назву радіосинтез.
«Енергія іонізуючого випромінювання приблизно в мільйон разів вища, ніж енергія білого світла, яке використовується у фотосинтезі», — розповіла BBC Катерина Дадачова, вчений-ядерник. — «Отже, вам потрібен досить потужний перетворювач енергії, і саме це, на нашу думку, здатний робити меланін — перетворювати іонізуюче випромінювання на корисні рівні енергії».
Космічний потенціал цвілі
Заінтриговані науковці міжнародної спільноти відправили зразки Cladosporium sphaerospermum — того ж самого штаму, виявленого в Чорнобилі, — на Міжнародну космічну станцію (МКС).
Зіткнувшись із інтенсивним космічним випромінюванням, гриби активно розмножувалися, показавши швидкість зростання у 1,21 раза вищу, ніж у контрольних зразків на Землі.
Цікаво, що експеримент на МКС також продемонстрував потенціал плісняви як захисного бар’єру. У міру розвитку гриби екранували значну кількість радіації порівняно з контрольними зонами.
З цих експериментів експерти припускають, що передбачувані радіозахисні переваги цвілі можуть бути зумовлені не виключно меланіном, а, можливо, іншими біологічними компонентами, такими як вода.
Галактичне космічне випромінювання, шторм високошвидкісних заряджених протонів від зірок, що вибухають, є «найбільшою небезпекою» для астронавтів, які вирушають за межі захисної атмосфери Землі.
Стандартні захисні рішення, такі як важкі метали, є дорогими та важкими для запуску в космос. Ця чорнобильська форма пропонує просту біологічну альтернативу.
Астробіологиня NASA Лінн Дж. Ротшильд пропонує концепцію «міко-архітектури»: створення житлових модулів із грибів безпосередньо на Місяці чи Марсі. Ці «живі стіни» не лише виконували б роль конструкції, але й були б самовідновлюваними екранами від радіації, вирощеними на місці, що дозволило б різко скоротити вартість космічних запусків.
https://dev.ua/news/zahadkovi-hryby-z-chornobylia-poidaiut-radiatsiiu-1764592448